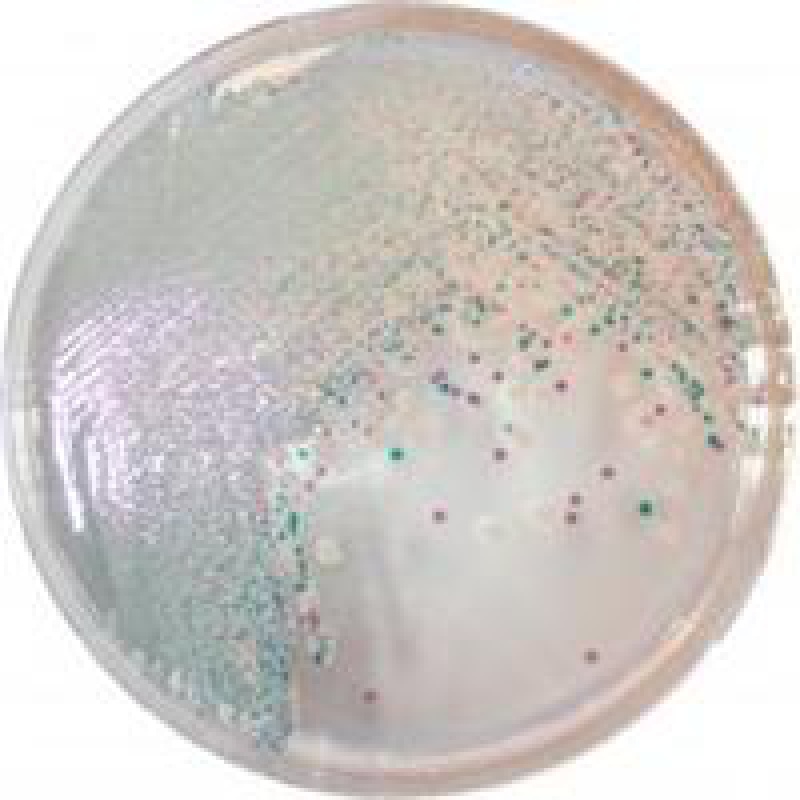
弧菌显色培养基平板9cm培养皿法国科玛嘉原料细菌培养皿 十个2f包 十
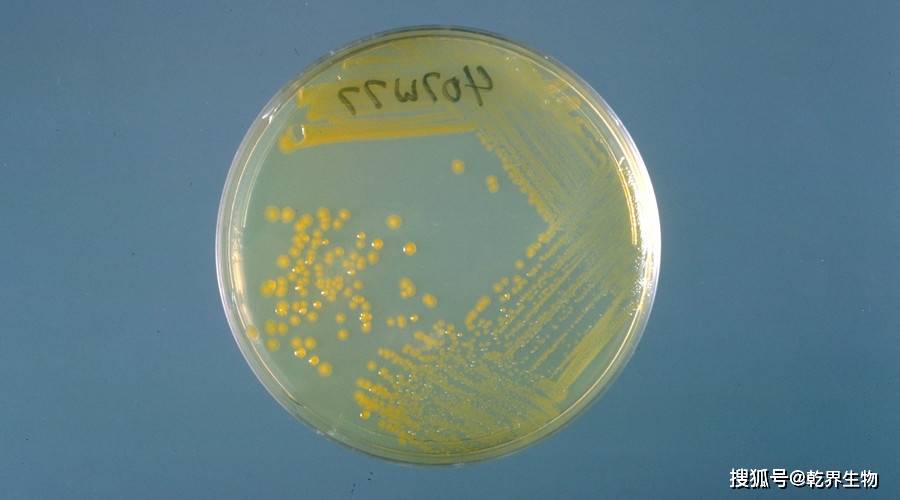
1克)1个③一次性无菌培养皿(90mm)10个④100ml量筒1个⑤三角烧瓶(500

弧菌培养皿

求助,科玛嘉的弧菌显色培养
图片尺寸1280x960
关于南美白对虾弧菌超标问题
图片尺寸2000x2667
技术| 五六月份,弧菌开始在对虾塘活动了,这份弧菌防控方案请拿好!
图片尺寸409x520
池塘的有害弧菌(培养皿检测)①雨后及时解毒雨后天晴,池塘水体环境不
图片尺寸640x480
虾苗弧菌数检测简易操作方法|培养基|培养皿|ml_网易订阅
图片尺寸435x320
形60弧菌不锈钢一次性90mm塑料用培养皿无菌7060mm一次性培养皿道
图片尺寸300x300
致病弧菌与对虾早期死亡综合征爆发的关系
图片尺寸720x1280
弧菌显色培养基平板9cm培养皿法国科玛嘉原料细菌培养皿 十个2f包 十
图片尺寸800x800
部分弧菌在培养基上的颜色
图片尺寸551x576
弧菌最让对虾养殖户头疼这款产品不仅能有效防控弧菌还无残留无刺激
图片尺寸900x437
将底泥加水稀释,提取稀释液均匀涂抹在弧菌培养皿中,放入恒温箱中进行
图片尺寸540x624
小龙虾养殖务必要小心池塘里的弧菌!否则雨后天晴就死虾!
图片尺寸554x585
蛭弧菌实验
图片尺寸911x1332
谈"弧菌"色变,但是至今你还没有见过它长什么样子
图片尺寸1280x1275
图5 霍乱弧菌非01氯化钠营养琼脂培养基生长结果2.
图片尺寸1000x1000
这几个要点,帮你轻松处理弧菌_养殖_对虾_繁殖
图片尺寸800x528
我们经常使用弧菌培养皿来测试弧菌的种类和数量.
图片尺寸613x650
南山生物科技南山金甸弧菌灵让你跟弧菌说拜拜
图片尺寸1080x734
1克)1个③一次性无菌培养皿(90mm)10个④100ml量筒1个⑤三角烧瓶(500
图片尺寸900x500
澄迈县无抗精华弧菌
图片尺寸370x800